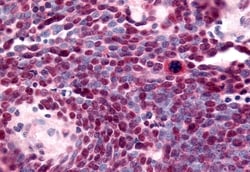
Invitrogen TLX Polyclonal Antibody 50 &mu;g; Unconjugated:Anticuerpos

missing translation for 'onlineSavingsMsg'
Learn More
Learn More
Invitrogen™ TLX Polyclonal Antibody


Descripción
TLX Polyclonal Antibody for IHC (P)
Nuclear receptor TLX, a NR2 hepatocyte NF4-like receptor, has been shown to affect anterior brain differentiation, retinal development, and vision. It has been suggested that TLX targets genes for RAR beta2 and Pax2 during retinal development. Homozygous TLX mutant mice are viable at birth but exhibit reduced forebrain development and are more aggressive than wild-type mice. Mice with deleted TLX locus exhibit cerebral hypoplasia, blindness, and extreme aggression (fierce (frc) phenotype). TLX expression has been documented in mouse brain and eye. ESTs have been isolated from normal human brain libraries.

Especificaciones
Especificaciones
| Antígeno | TLX |
| Aplicaciones | Immunohistochemistry (Paraffin) |
| Clasificación | Polyclonal |
| Concentración | 1 mg/mL |
| Conjugado | Unconjugated |
| Formulación | PBS with 0.1% sodium azide |
| génica | NR2E1 |
| N.º de referencia del gen | Q9Y466 |
| Alias de gen | fc30e03; fc39f12; fierce; frc; HTll; Mtl1; Mtll; NR2D1; nr2e1; Nuclear receptor subfamily 2 group E member 1; nuclear receptor subfamily 2, group E, member 1; nuclear receptor TLX; Protein tailless homolog; tailes-related receptor; tailless; tailless homolog; TLL; Tlx; wu:fc30e03; wu:fc39f12; XTLL; zgc:100991 |
| Símbolos de los genes | NR2E1 |
| Mostrar más |
Título del producto
Al hacer clic en Enviar, acepta que Fisher Scientific se ponga en contacto con usted en relación con los comentarios que ha proporcionado en este formulario. No compartiremos su información para ningún otro fin. Toda la información de contacto proporcionada se mantendrá de acuerdo con nuestra Política de Privacidad. Política de privacidad.
¿Detecta una oportunidad de mejora?